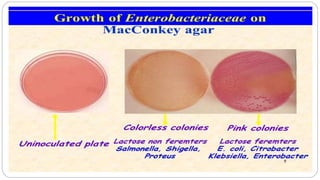

The document discusses the classification of bacteria according to Bergey's Manual of Systematic Bacteriology. It is divided into 5 volumes based on phylogenetic analysis of rRNA, DNA and proteins. The first volume covers Archaea, cyanobacteria and other phototrophic bacteria. Important sections in Archaea include hyperthermophiles, methanogens, and halobacteria. Characteristics of these groups are provided. The second volume covers Proteobacteria which are further divided into 5 classes - Alpha, Beta, Gamma, Delta and Epsilon proteobacteria. Examples of some bacteria from each class are given along with their characteristics.